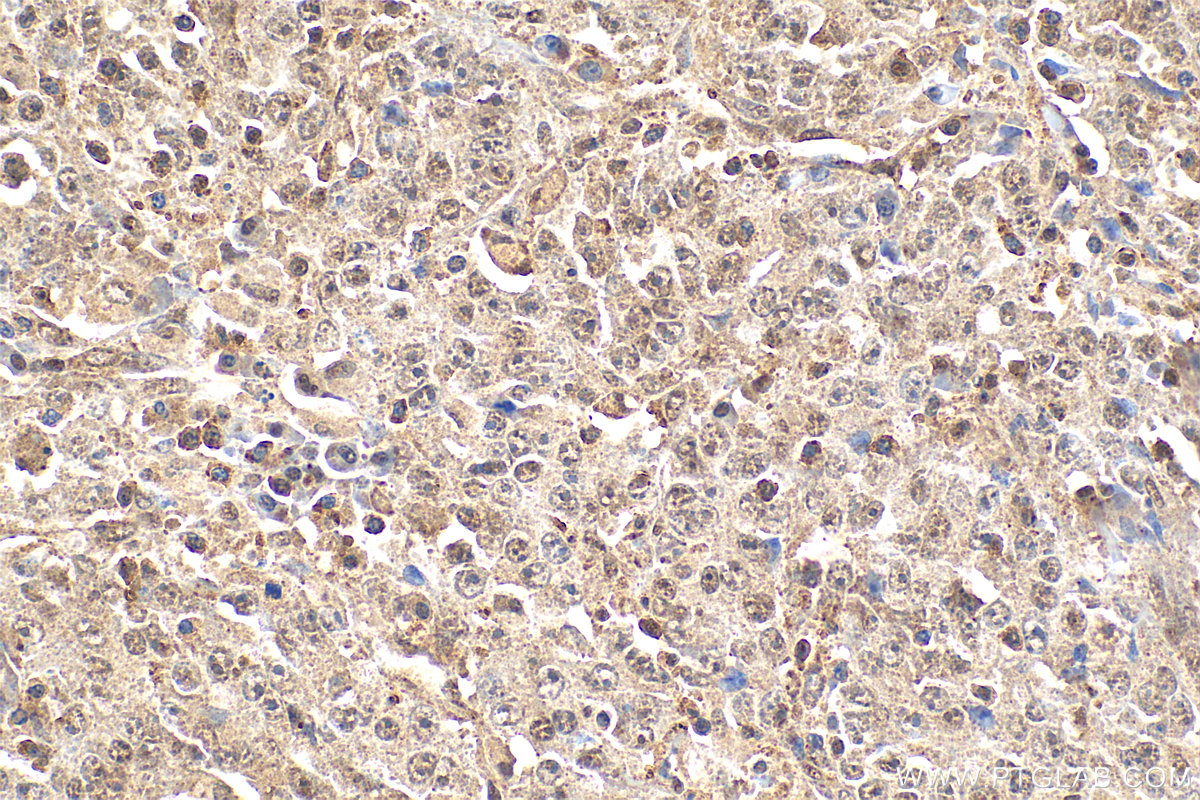
IHC staining of human lymphoma using 12133-2-AP

验证数据展示
经过测试的应用
| Positive WB detected in | COLO 320 cells, Jurkat cells, mouse spleen tissue, mouse thymus tissue, Raji cells, Caco-2 cells, Daudi cells |
| Positive IP detected in | Jurkat cells |
| Positive IHC detected in | human lymphoma tissue, mouse brain tissue Note: suggested antigen retrieval with TE buffer pH 9.0; (*) Alternatively, antigen retrieval may be performed with citrate buffer pH 6.0 |
| Positive IF/ICC detected in | L02 cells, HepG2 cells, HeLa cells, sodium arsenite treated HeLa cells |
| Positive FC (Intra) detected in | HeLa cells |
推荐稀释比
| 应用 | 推荐稀释比 |
|---|---|
| Western Blot (WB) | WB : 1:5000-1:50000 |
| Immunoprecipitation (IP) | IP : 0.5-4.0 ug for 1.0-3.0 mg of total protein lysate |
| Immunohistochemistry (IHC) | IHC : 1:400-1:1600 |
| Immunofluorescence (IF)/ICC | IF/ICC : 1:50-1:500 |
| Flow Cytometry (FC) (INTRA) | FC (INTRA) : 0.40 ug per 10^6 cells in a 100 µl suspension |
| It is recommended that this reagent should be titrated in each testing system to obtain optimal results. | |
| Sample-dependent, Check data in validation data gallery. | |
产品信息
12133-2-AP targets TIA1 in WB, IHC, IF/ICC, FC (Intra), IP, CoIP, ChIP, RIP, ELISA applications and shows reactivity with human, mouse, rat samples.
| 经测试应用 | WB, IHC, IF/ICC, FC (Intra), IP, ELISA Application Description |
| 文献引用应用 | WB, IHC, IF, CoIP, ChIP, RIP |
| 经测试反应性 | human, mouse, rat |
| 文献引用反应性 | human, mouse, rat, pig, chicken |
| 免疫原 |
CatNo: Ag2778 Product name: Recombinant human TIA1 protein Source: e coli.-derived, PGEX-4T Tag: GST Domain: 1-214 aa of BC015944 Sequence: MEDEMPKTLYVGNLSRDVTEALILQLFSQIGPCKNCKMIMDTAGNDPYCFVEFHEHRHAAAALAAMNGRKIMGKEVKVNWATTPSSQKKDTSSSTVVSTQRSQDHFHVFVGDLSPEITTEDIKAAFAPFGRISDARVVKDMATGKSKGYGFVSFFNKWDAENAIQQMGGQWLGGRQIRTNWATRKPPAPKSTYECRCIGEEKEMWNFGEKYARF 种属同源性预测 |
| 宿主/亚型 | Rabbit / IgG |
| 抗体类别 | Polyclonal |
| 产品类型 | Antibody |
| 全称 | TIA1 cytotoxic granule-associated RNA binding protein |
| 别名 | Cytotoxic granule associated RNA binding protein TIA1, Nucleolysin TIA-1 isoform p40, p40 TIA 1, p40-TIA-1, RNA binding protein TIA 1 |
| 计算分子量 | 214 aa, 24 kDa, 43 kDa |
| 观测分子量 | ~40 kDa |
| GenBank蛋白编号 | BC015944 |
| 基因名称 | TIA1 |
| Gene ID (NCBI) | 7072 |
| RRID | AB_2201427 |
| 偶联类型 | Unconjugated |
| 形式 | Liquid |
| 纯化方式 | Antigen affinity purification |
| UNIPROT ID | P31483 |
| 储存缓冲液 | PBS with 0.02% sodium azide and 50% glycerol, pH 7.3. |
| 储存条件 | Store at -20°C. Stable for one year after shipment. Aliquoting is unnecessary for -20oC storage. |
背景介绍
TIA1, also named as p40-TIA-1, is involved in alternative pre-RNA splicing and regulation of mRNA translation by binding to AU-rich elements (AREs) located in mRNA 3' untranslated regions (3' UTRs). It possesses nucleolytic activity against cytotoxic lymphocyte target cells. TIA1 may be involved in apoptosis. Two isoforms of this protein exist - 41kDa and 42kDa. one of these was a missense variant (P362L) in TIA1. Similar to the ALS-related disease proteins TDP-43, hnRNPA1, and FUS, TIA1 is an RNA-binding protein containing a prionlike LCD and assembles into membrane-less organelles, including SGs. Postmortem neuropathology of five TIA1mutations carriers showed a consistent pathological signature with numerous round, hyaline, TAR DNA-binding protein 43 (TDP-43)-positive inclusions.TIA1mutations significantly increased the propensity of TIA1 protein to undergo phase transition. In live cells,TIA1mutations delayed stress granule (SG) disassembly and promoted the accumulation of non-dynamic SGs that harbored TDP-43. Moreover, TDP-43 in SGs became less mobile and insoluble.
实验方案
| Product Specific Protocols | |
|---|---|
| FC protocol for TIA1 antibody 12133-2-AP | Download protocol |
| IF protocol for TIA1 antibody 12133-2-AP | Download protocol |
| IHC protocol for TIA1 antibody 12133-2-AP | Download protocol |
| IP protocol for TIA1 antibody 12133-2-AP | Download protocol |
| WB protocol for TIA1 antibody 12133-2-AP | Download protocol |
| Standard Protocols | |
|---|---|
| Click here to view our Standard Protocols |
发表文章
| Species | Application | Title |
|---|---|---|
Cell In vivo structural characterization of the SARS-CoV-2 RNA genome identifies host proteins vulnerable to repurposed drugs.
| ||
Cell Res Predicting dynamic cellular protein-RNA interactions by deep learning using in vivo RNA structures. | ||
Nat Struct Mol Biol TDP-43 aggregation induced by oxidative stress causes global mitochondrial imbalance in ALS. | ||
Neuron TIA1 Mutations in Amyotrophic Lateral Sclerosis and Frontotemporal Dementia Promote Phase Separation and Alter Stress Granule Dynamics. | ||
Nat Commun Cellular stress alters 3'UTR landscape through alternative polyadenylation and isoform-specific degradation. | ||
Brain Defective cyclophilin A induces TDP-43 proteinopathy: implications for amyotrophic lateral sclerosis and frontotemporal dementia |